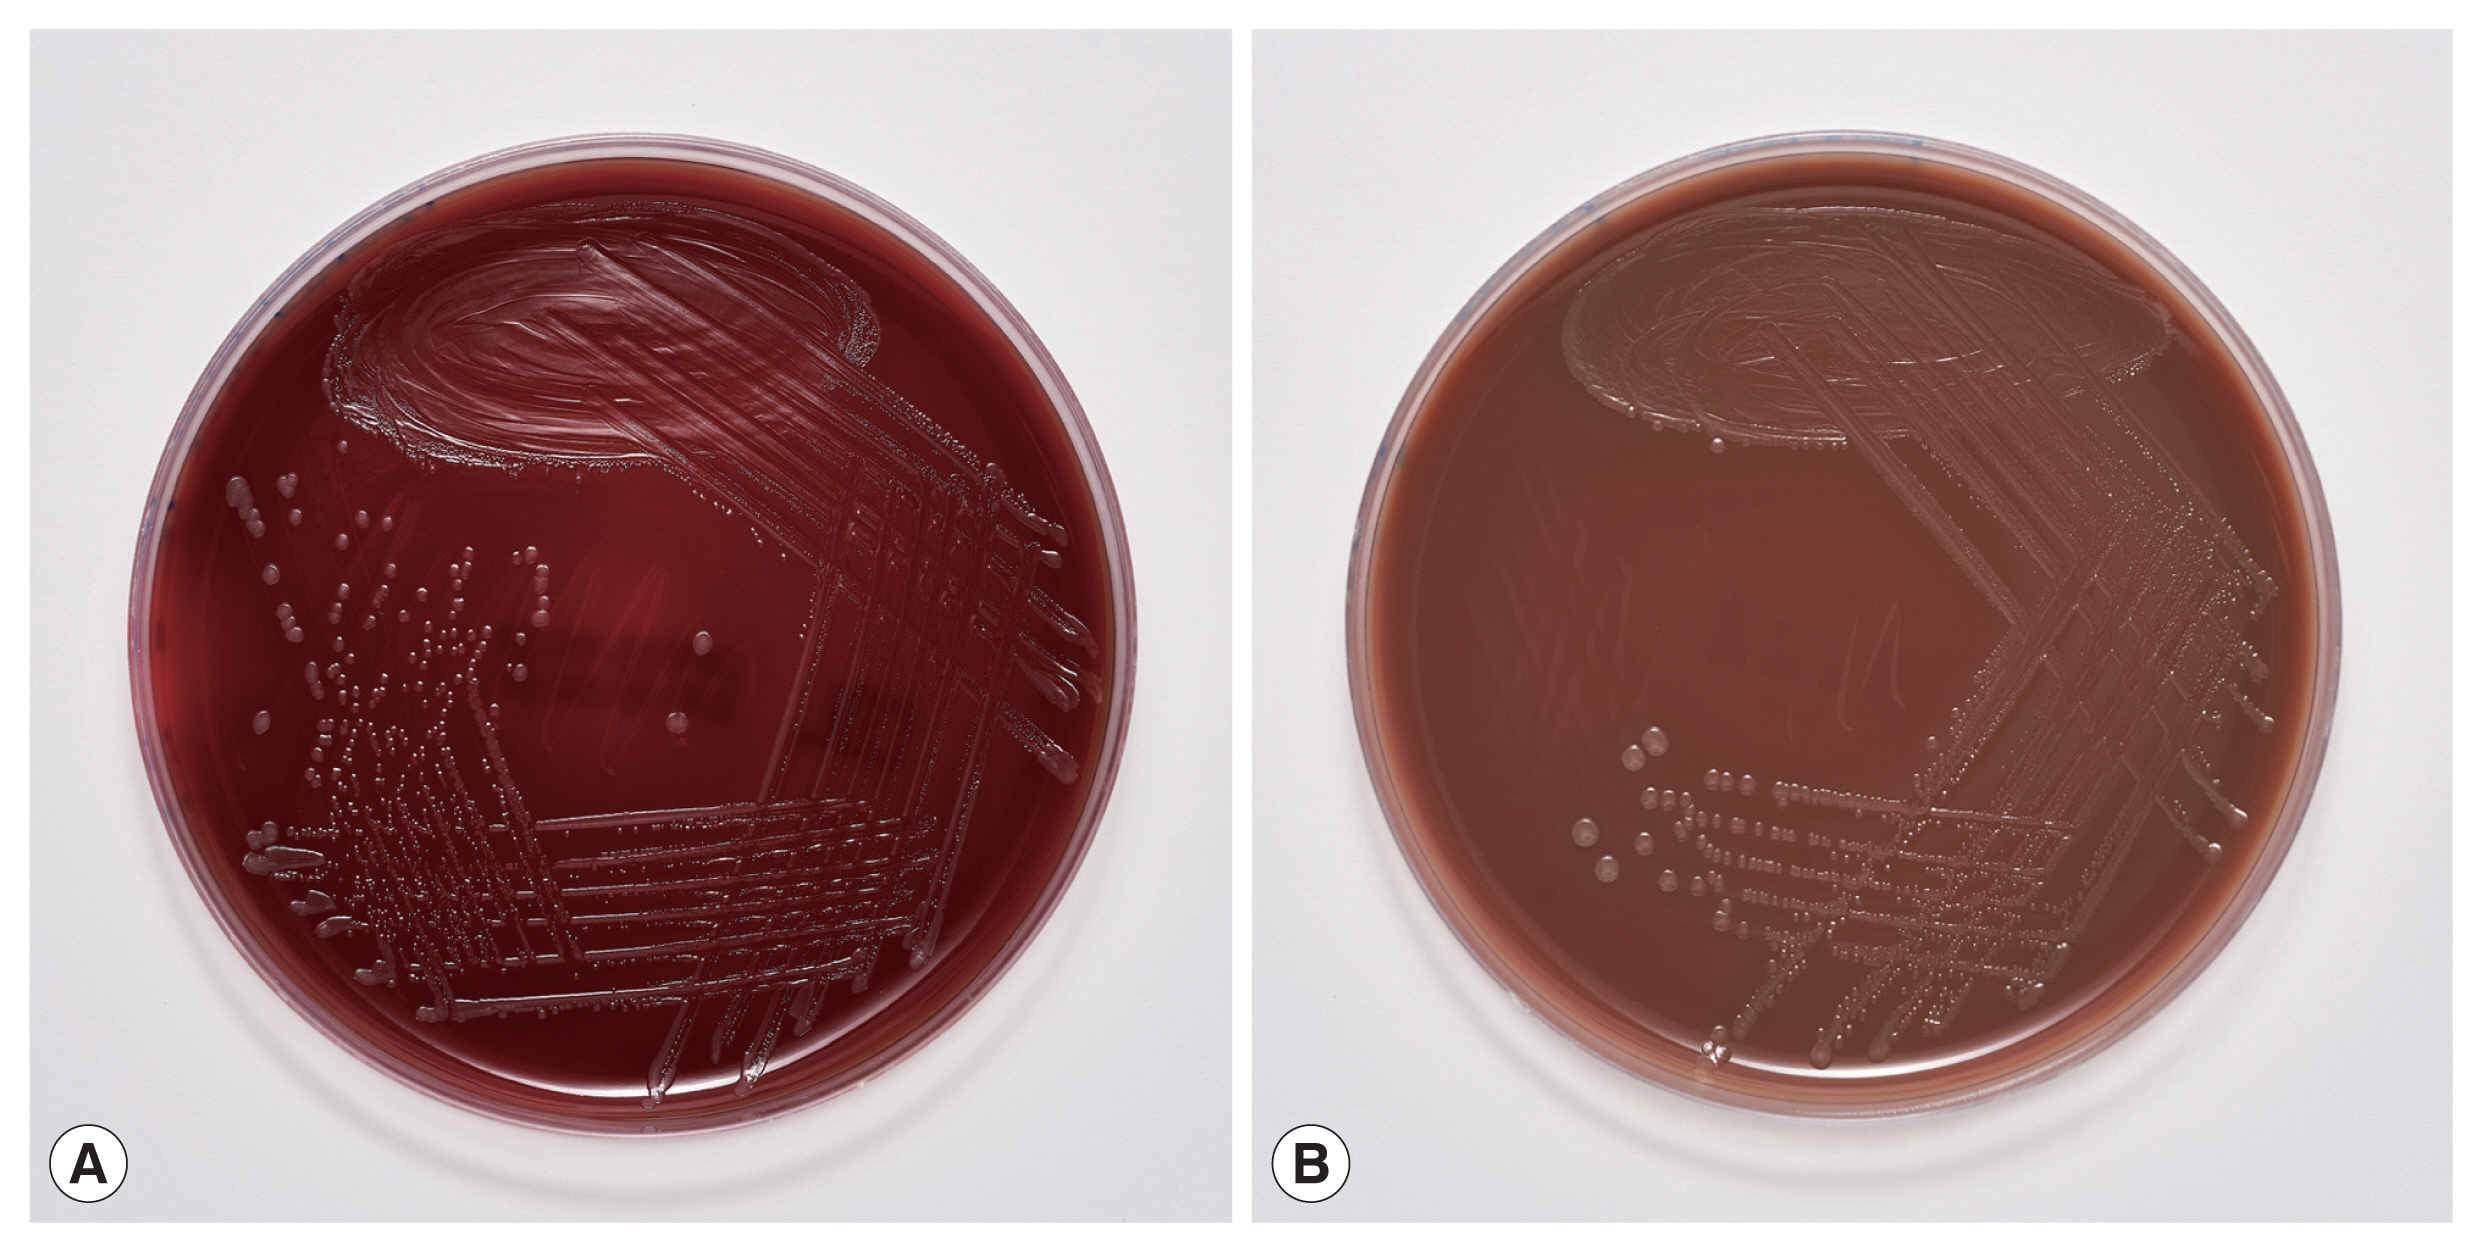
2

INTRODUCTION
Myiasis is an infestation of humans and other vertebrates by various dipteran larvae that feed on the host’s dead or living tissues, body secretions, or ingested food [
1,
2]. Human myiasis is more common in poor socioeconomic regions of tropical and subtropical countries, whereas in industrialized countries of temperate climates it is usually associated with travel or precarious living conditions [
1,
3]. According to the classification of myiasis in relation to the location on the host, the infestation is classified into sanguinivorous or bloodsucking myiasis, cutaneous, furuncular, and migratory myiasis, wound myiasis, and cavitary myiasis [
1]. The most important family of flies causing wound myiasis is Calliphoridae, with
Calliphora,
Lucilia,
Chrysomyia, and
Cochliomyia as the most causative genera.
Lucilia spp. are present in South Africa, Australia, Europe, and North America. Their larvae prefer to feed on dead tissue, usually causing facultative open wound myiasis [
1,
4]. Exposed lesions attract and stimulate females to oviposit [
1]. Because flies and their larvae are hosts to bacteria, there are possibilities of secondary bacterial infections of the lesions and bacteremia if the bacteria invade the bloodstream. The bacteria most often associated with myiasis-induced bacteremia are
Wohlfahrtiimonas spp. and
Ignatzschineria spp. [
5]. Both genera are well known inhabitants of the larvae of many fly species [
6]. In the salivary glands of
Lucilia spp. bacteria of the genus
Ignatzschineria have been found in relatively high abundance [
7]. Here we describe a case of myiasis with subsequent
Ignatzschineria larvae circulatory infection, presumably as a complication of a
Lucilia sp. maggot wound infestation in a young male migrant.
CASE DESCRIPTION
The ethic review was exempted by the Institutional Review Board of the Institute of Microbiology and Immunology (IMI), Faculty of Medicine, University of Ljubljana, Slovenia (IRB No. 469-TJI/20). All procedures followed were in accordance with the ethical standards of the institutional and national committee on human experimentation and with the Helsinki Declaration as revised in 2013. The patient samples were collected for diagnostic purposes as a part of a routine diagnostic procedure of the IMI. The patient was informed about all diagnostic procedures, and steps were taken to preserve patient anonymity. All samples were anonymized and linked only to randomized numerical codes. Since no additional samples or data were collected, the study was deemed to be low risk and the need for additional ethical permission from the National Medical Ethics Committee was waived.
In September 2019, an 18-year-old male patient, an irregular migrant from Asia, was admitted to the Department of Infectious Diseases, University Medical Centre Ljubljana, Slovenia, after being detained while crossing the border river between Slovenia and Croatia. He had left his home country approximately 2 years before this incident and was travelling on foot in rural areas and woodlands of the Balkans. After falling off a rock 3 days prior to admission, he reported subsequent abdominal pain and pain in the left leg. He had not eaten or had a bowel movement for several days; he had vomited once before admission but passed urine normally. He had no underlying comorbidities, but he reported an allergy due to which he was taking an antihistamine. Physical examination revealed that he was in pain, febrile (39.6°C), and normotensive (blood pressure 114/65 mm Hg) with tachycardia (130 beats/min), and tenderness in the right lower quadrant of the abdomen. There were multiple superficial wounds on both the calves and feet with surrounding cellulitis, which had spread proximally to the right thigh, and tenderness and swelling of the left knee. No accompanying lymphadenopathy was visible. The middle finger of his left hand was also swollen and tender. Numerous small moving white larvae were observed on the skin of the legs, in both armpits, in the perigenital region, and in the skin folds. The wounds were debrided, and all the visible larvae were removed. Urinary retention was noted, and a urinary catheter inserted. Laboratory results revealed an elevated C-reactive protein (CRP) level (499 mg/L), a procalcitonin (PCT) level of 8.94 ng/ml, and leukocytosis of 25.9× 109/L with a left shift (8% bands and 3% metamyelocytes). Acute renal insufficiency was present (plasma creatinine of 168 μmol/L, upper limit 97 μmol/L; and urea of 24.2 mmol/L, upper limit of 7.5 mmol/L). The patient had mild hyponatremia (130 mmol/L, lower limit 135 mmol/L), increased myoglobin of 553.4 μg/L (upper limit 110 μg/L), mild elevations of transaminases (AST 2.63 μkat/L, upper limit 0.52 μkat/L; S-ALT 1.38 μkat/L upper limit 0.57 μkat/L), and increased D-dimer (4,683 μg/L, upper limit 500 μg/L). A soft tissue ultrasound of the right thigh showed cellulitis. Blood cultures were taken, and the patient was started on empirical intravenous antibiotic therapy with flucloxacillin 2 g every 6 hr and ciprofloxacin 400 mg every 12 hr. Following treatment, the patient was afebrile the next day. The patient continued to receive supportive therapy with antipyretics, analgesics, and parenteral hydration, upon which the kidney function normalized within 4 days. A blood smear for malaria was negative. In accordance with our institutional guidelines, surveillance samples were taken on admission. A rectal swab yielded ESBL-producing Enterobacter cloacae, and the pooled skin swab samples grew methicillin-resistant Staphylococcus aureus. Samples for other multidrug resistant organisms were negative.
The wounds were redressed 2 days later, with numerous larvae observed on the calf wounds, in the blisters surrounding the calf wounds, and under the toenails of several toes. All visible larvae were removed and additional debridement of dead skin surrounding the wounds was performed. Where the larvae were rooted in the nailbed, the overlying nails were ablated and the larvae extracted. The area was cleaned with a 3% solution of hydrogen peroxide and dressed. The patient became febrile again within hours after the second debridement, and therefore 2 blood culture sets, each containing one aerobic (BD BACTEC Plus Aerobic/F, Becton Dickinson, Franklin Lakes, New Jersey, USA) and one anaerobic (BD BACTEC Lytic Anaerobic/F, Becton Dickinson) bottle were drawn again and, due to an increase in leukocytosis to 33.1×109/L, antibiotic therapy was changed to tigecycline and vancomycin. The patient was hypotensive the next day (blood pressure 88/55 mm Hg) accompanied by vomiting. We changed tigecycline to imipenem/cilastatin 500 mg every 6 hr i.v. but continued with vancomycin 1 g every 12 hr i.v. Hypotension resolved after a fluid bolus. Acute bowel obstruction was excluded by abdominal radiograph and severe obstipation diagnosed, which was resolved by enema.
The larvae were sent to the IMI at the Faculty of Medicine in Ljubljana, Slovenia, for identification, where they were preserved in 10% formalin solution. The genus
Lucilia was confirmed macroscopically and microscopically at the IMI through their morphological characteristics using the identification key to fly larvae [
8]. The larvae were 9 to 10 mm long, round in cross section, tapered anteriorly, and white to cream colored. All of them were in larval stage III (3rd instar) of their life cycle. In the mouthparts an accessory oral sclerite was absent. The dorsal arm of the cephaloskeleton was longer than the ventral arm. The bodies of the larvae had short spines (
Fig. 1A). The posterior spiracles were located on the face of the terminal segment, sessile with 3 distinct straight slits surrounded by a complete closed peritremal ring with one internal projection between the outer and middle slits and a distinct button (
Fig. 1B, C). The spiracular area was surrounded by 12 tubercles.
The blood cultures drawn on admission were sterile. However, of the 2 blood culture sets drawn after the second wound debridement, one anaerobic bottle was reported positive by the BD BACTEC FX blood culture system (Becton Dickinson), and Gram staining revealed Gram-negative rods (
Fig. 2). Identification of bacteria directly from positive blood culture using matrix-assisted laser desorption/ionization time-of-flight mass spectrometry (MALDI-TOF MS) (Bruker Daltonics, Server version 4.1.70 (PYTH) 48 2016-10-26_15-05-35, Billerica, Massachusetts, USA) [
9] was not successful. Subculturing resulted in the growth of colonies with a yellowish pigment on Columbia and chocolate agar (
Fig. 3) after 18 hr of incubation. No growth was observed on anaerobically incubated growth media. The identification of bacteria by MALDI-TOF MS was unsuccessful also from subculture. The strain was identified as
Ignatzschineria sp. by partial (320 bp long region) 16S ribosomal ribonucleic acid (16S rRNA) gene sequencing [
10]. By sequencing a longer 1,462 bp region of the 16S rRNA gene [
11], the strain was identified as
Ignatzschineria larvae with an identity match of 99.9%. The nucleotide sequence was deposited in the GenBank database under the accession number MW420873. The identity match with the most closely related species was 99.2% for
Ignatzschineria ureiclastica and 98.5% for
Ignatzschineria indica (
Fig. 4). Testing of antibiotic susceptibility was done using Etests (Liofilchem, Roseto degli Abruzzi, Italy or bioMerieux, Marcy-l’Étoile, France). The isolated strain of
I. larvae was reported susceptible to piperacillin-tazobactam, ceftazidime, ciprofloxacin, and imipenem considering pharmacodynamic/pharmacokinetic (non-species related) European Committee on Antimicrobial Susceptibility Testing (EUCAST) Clinical breakpoints [
12].
After the second debridement, no more larvae were observed in the wounds, which were redressed regularly and were healing well. A swelling was observed on the proximal right thigh, and therefore an abscess was suspected and ultrasound performed, which showed only lymphadenopathy. Because tularemia is present in the rural Western Balkans [
13], a punctate of the lymph nodes was sent to the IMI for PCR for
Francisella tularensis, which was negative. Serology for
Bartonella spp.,
Francisella tularensis, and
Toxoplasma gondii were also negative. Thus, lymph node enlargement was likely only due to skin and soft tissue infections.
After receiving 10 days of appropriate antibiotic therapy, the patient’s clinical condition improved and biomarkers of inflammation resolved. He was afebrile from the 5th day onward and was discharged to a detention center. He was then lost to follow-up.
DISCUSSION
This is the first reported human case of
Ignatzschineria spp. bacteremia in Slovenia.
Ignatzschineria spp. are emerging aerobic, Gram-negative, non-sporulating, non-haemolytic, non-motile, rod-shaped bacteria that were first isolated from larvae of
Wohlfahrtia magnifica, a parasitic flesh fly causing myiasis in several animal species and occasionally in humans [
14–
17]. Recent reports suggest that
Ignatzschineria spp. may also be transmitted by flies from the genus
Lucilia, which are more commonly associated with human wound myiasis [
5,
6]. Bacteria carried by fly larvae can spread into the bloodstream of the infested host, causing serious systemic infections. However, bacteremia in humans caused by species of the genus
Ignatzschineria has been rarely described and has only been documented in a few case reports [
5,
6,
15,
18–
27]. The rarity of infections being detected may be due to the fact that these bacteria were first described only 2 decades ago and also the difficulty of their identification using standard medical microbiology identification methods, such as classical biochemical tests and commercial bacterial identification systems [
18]. Recent inclusion of reference spectra for a representative strain of
Ignatzschineria indica in the Bruker database may make possible more frequent identification of this species by MALDI-TOF MS in the future [
19,
28]. Indeed, as reported by Rodriguez-Zuniga et al. [
24], Deslandes et al. [
19], and Snyder et al. [
26],
I. indica from blood cultures of patients with sepsis or bacteremia has correctly been identified by MALDI-TOF MS. As shown in our case, the identification of the species
I. larvae by MALDI-TOF MS was still not possible.
Currently, the most accurate method for identifying
Ignat- zschineria spp. is 16S rRNA gene sequencing. In fact, it was the only way for accurate identification of the species
Ignatzschineria larvae in our case. Heddema et al. [
21] reported very high similarity among 16S rRNA sequences of
I. ureiclastica,
I. larvae and
I. indica, 3 out of the 4 species described so far in the genus
Ignatzschineria. By the initial sequencing of a 320 bp long region of the 16S rRNA gene [
10] we were able to identify the bacterium, which caused bacteremia in our patient, at the genus level only. For this reason, sequencing of a 1,462 bp long region of the same gene [
11] was required for accurate identification of
I. larvae. To date, there have been 4 other case reports describing
I. larvae bacteremia in patients with myiasis, all of them originating from France [
20,
22,
25,
27]. As in most of the described cases of
Ignatzschineria spp. infections associated with myiasis, in these 4 case reports the maggots were discarded after wound cleaning and were not sent for entomological identification. To the best of our knowledge, there is only one case report in which the maggots were identified and
Lucilia sericata connected to
I. indica bacteremia was determined [
6]. The maggots from the wounds of our patient were preserved in formalin immediately upon submission to the IMI. The preservation killed the larvae, made them immotile, and thus made their identification possible.
Lucilia sp. was identified based on the maggots’ morphological appearance. Unfortunately, the preservation prevented their subsequent bacterial analysis. Hence, it was impossible to confirm that
I. larvae causing bacteremia in our patient formed part of the flora of these maggots. However, a relation between
Ignatzschineria spp. infection and maggot infestation is well documented [
5,
6,
25]. Thus, our hypothesis that the bacteremia originated from maggots infesting the patient’s wounds is reasonable. Moreover, the bacterium grew only in the second set of blood cultures, which were drawn after wound debridement that involved nail ablation and necrectomy. We believe it is likely that the wound manipulation caused invasion of the bacteria into the bloodstream and a second spike of fever despite concomitant antibiotic therapy.
As discussed above,
Lucilia spp. maggots are among the most common maggots infesting human wounds [
6]. Community-acquired myiasis by these larvae poses a risk for serious systemic bacterial infections [
5,
18]. On the other hand, sterile medical-grade larvae of
Lucilia species are very effective at wound cleaning and are therefore used in one of the oldest techniques in wound care, known as maggot debridement therapy or biosurgery [
29]. Biosurgery has been acceleratingly reintroduced in healing of chronically infected wounds since the appearance of bacterial strains with antibiotic resistance [
30].
Our patient was an irregular migrant from Asia using the western Balkan migration route to reach western Europe. This route is one of the main migration routes into Europe. In 2019, around 14,000 illegal crossings were identified on the European Union’s borders on the western Balkan route alone, more than double the 2018 statistics [
31]. In Slovenia, a total of 16,099 illegal crossings of the border were recorded in 2019. The number increased by 73.8% compared to 2018 [
32]. Given the increasing number of illegal border crossings, myiasis and myiasis-induced bacteremia could become an important migrant health issue.
Clinicians should have a high level of suspicion when treating patients with neglected wounds. Just as myiasis may indicate an underlying bacterial infection, the presence of bacteremia with
Ignatzschineria spp. or
Wohlfahrtiimonas spp. –another maggot-associated bacteria that have caused episodes of bacteremia–may indicate myiasis [
5]. We would like to emphasize that standard biochemical tests and automated identification systems do not always identify these emerging pathogens. We therefore believe that cases like ours need to be reported.
Notes
-
The authors declare no conflict of interest related to this study.
ACKNOWLEDGMENTS
We would like to thank Luka Šparl for taking photos of Lucilia sp. larvae and Marko Kolenc for taking photos of Ignatzschineria larvae grown on agar plates. This work was supported by the Slovenian Research Agency (grant number P3-0083).
Fig. 1
Lucilia sp. 3rd instar larva from our patient. (A) Thoracic segment spines. (B) Posterior spiracles with 3 distinct straight slits surrounded by a complete closed peritremal ring with one internal projection between the outer and middle slits; the spines and the posterior spiracles were photographed using a Nikon Eclipse E600 (Nikon, Tokyo, Japan) microscope and DS-Fi1 (Nikon) camera. (C) Posterior spiracles located on the face of the terminal segment.

Fig. 2
Ignatzschineria larvae from pure bacterial culture: Gram stain.

Fig. 3Culture of Ignatzschineria larvae grown on (A) Columbia agar and (B) chocolate agar after 18-hour incubation.

Fig. 4Neighbour-Joining phylogenetic tree based on nearly full-length 16S rRNA gene sequence of Ignatzschineria larvae isolate BM1043 from our patient (in boldface) and representative Ignatzschineria sp. sequences retrieved from GenBank. The tree was created with MEGA 7.0 software using the Neighbour-Joining method and Jukes–Cantor model. Values on branches are percentage bootstrap values using 1,000 replicates. Wohlfahrtiimonas chitiniclastica was included as an outgroup organism.

References
- 1. Francesconi F, Lupi O. Myiasis. Clin Microbiol Rev 2012;25:79-105. https://doi.org/10.1128/CMR.00010-11
- 2. Gour S, Ramesh G, Kumar V, Thapliyal GK, Nagarajappa R. Cavitary myiasis and its management. J Exp Ther Oncol 2018;12:211-216.
- 3. Caumes E, Carriere J, Guermonprez G, Bricaire F, Danis M, Gentilini M. Dermatoses associated with travel to tropical countries: a prospective study of the diagnosis and management of 269 patients presenting to a tropical disease unit. Clin Infect Dis 1995;20:542-548. https://doi.org/10.1093/clinids/20.3.542
- 4. Bonwitt JH, Tran M, Dykstra EA, Eckmann K, Bell ME, Leadon M, Sixberry M, Glover WA. Fly reservoir associated with Wohlfahrtiimonas bacteremia in a human. Emerg Infect Dis 2018;24:370-373. https://doi.org/10.3201/eid2402.170913
- 5. Lysaght TB, Wooster ME, Jenkins PC, Koniaris LG. Myiasis-induced sepsis: a rare case report of Wohlfahrtiimonas chitiniclastica and Ignatzschineria indica bacteremia in the continental United States. Medicine (Baltimore) 2018;97:e13627. https://doi.org/10.1097/MD.0000000000013627
- 6. Barker HS, Snyder JW, Hicks AB, Yanoviak SP, Southern P, Dhakal BK, Ghimire GR, Couturier MR. First case reports of Ignatzschineria (Schineria) indica associated with myiasis. J Clin Microbiol 2014;52:4432-4434. https://doi.org/10.1128/JCM.02183-14
- 7. Singh B, Crippen TL, Zheng L, Fields AT, Yu Z, Ma Q, Wood TK, Dowd SE, Flores M, Tomberlin JK, Tarone AM. A metagenomic assessment of the bacteria associated with Lucilia sericata and Lucilia cuprina (Diptera: Calliphoridae). Appl Microbiol Biotechnol 2015;99:869-883. https://doi.org/10.1007/s00253-014-6115-7
- 8. National Center for Environmental Health. Pictorial keys to arthropods, reptiles, birds, and mammals of public health significance [Internet]; Atlanta, USA: U.S. Department of Health and Human Services, Centers for Disease Control and Prevention; [cited 2020 Mar 7]. Available from: https://www.cdc.gov/nceh/ehs/Publications/Pictorial_Keys.htm
- 9. Martiny D, Dediste A, Vandenberg O. Comparison of an in-house method and the commercial Sepsityper kit for bacterial identification directly from positive blood culture broths by matrix-assisted laser desorption-ionisation time-of-flight mass spectrometry. Eur J Clin Microbiol Infect Dis 2012;31:2269-2281. https://doi.org/10.1007/s10096-012-1566-1
- 10. Harris KA, Hartley JC. Development of broad-range 16S rDNA PCR for use in the routine diagnostic clinical microbiology service. J Med Microbiol 2003;52:685-691. https://doi.org/10.1099/jmm.0.05213-0
- 11. Kawahara M, Rikihisa Y, Lin Q, Isogai E, Tahara K, Itagaki A, Hiramitsu Y, Tajima T. Novel genetic variants of Anaplasma phagocytophilum, Anaplasma bovis, Anaplasma centrale, and a novel Ehrlichia sp. in wild deer and ticks on two major islands in Japan. Appl Environ Microbiol 2006;72:1102-1109. https://doi.org/10.1128/AEM.72.2.1102-1109.2006
- 12. European Committee on Antimicrobial Susceptibility Testing (EUCAST). Breakpoint tables for interpretatation of MICs and zone diameters. Version 9.0; 2019. [Internet]; [cited 2020 May 4]. Available from: https://www.eucast.org/fileadmin/src/media/PDFs/EUCAST_files/Breakpoint_tables/v_9.0_Breakpoint_Tables.pdf
- 13. Gurcan S. Epidemiology of tularemia. Balkan Med J 2014;31:3-10. https://doi.org/10.5152/balkanmedj.2014.13117
- 14. Gupta AK, Dharne MS, Rangrez AY, Verma P, Ghate HV, Rohde M, Patole MS, Shouche YS. Ignatzschineria indica sp. nov. and Ignatzschineria ureiclastica sp. nov., isolated from adult flesh flies (Diptera: Sarcophagidae). Int J Syst Evol Microbiol 2011;61:1360-1369. https://doi.org/10.1099/ijs.0.018622-0
- 15. Le Brun C, Gombert M, Robert S, Mercier E, Lanotte P. Association of necrotizing wounds colonized by maggots with Ignatzschineria-associated septicemia. Emerg Infect Dis 2015;21:1881-1883. https://doi.org/10.3201/eid2110.150748
- 16. Toth E, Kovacs G, Schumann P, Kovacs AL, Steiner U, Halbritter A, Marialigeti K. Schineria larvae gen. nov., sp. nov., isolated from the 1st and 2nd larval stages of Wohlfahrtia magnifica (Diptera: Sarcophagidae). Int J Syst Evol Microbiol 2001;51:401-407. https://doi.org/10.1099/00207713-51-2-401
- 17. Toth EM, Hell E, Kovacs G, Borsodi AK, Marialigeti K. Bacteria isolated from the different developmental stages and larval organs of the obligate parasitic fly, Wohlfahrtia magnifica (Diptera: Sarcophagidae). Microb Ecol 2006;51:13-21. https://doi.org/10.1007/s00248-005-0090-6
- 18. Cipolla L, Derdoy L, Archuby D, Tarzia A, Govedic F, Prieto M. Sepsis secondary to complicated skin and soft tissue infection caused by Ignatzschineria indica. First case report in Latin America. JMM Case Rep 2018;5:e005151. https://doi.org/10.1099/jmmcr.0.005151
- 19. Deslandes V, Haney C, Bernard K, Desjardins M. Ignatzschineria indica bacteremia in a patient with a maggot-infested heel ulcer: a case report and literature review. Access Microbiol 2020;2. https://doi.org/10.1099/acmi.0.000078
- 20. Grasland O, Donnio PY, Jego P, Tattevin P, Alix L. Ignatzschineria larvae bacteremia and osteitis on a chronic wound infested by maggots. Med Mal Infect 2020;50:452-454. (in French). https://doi.org/10.1016/j.medmal.2020.01.005
- 21. Heddema E, Janssen F, van Westreenen H. A case of Ignatzschineria bacteraemia in an unconscious man from the Netherlands. JMM Case Rep 2016;3:e005043. https://doi.org/10.1099/jmmcr.0.005043
- 22. Maurin M, Delbano JN, Mackaya L, Colomb H, Guier C, Mandjee A, Recule C, Croize J. Human infection with Schineria larvae. Emerg Infect Dis 2007;13:657-659. https://doi.org/10.3201/eid1304.061151
- 23. Muse H, Jenkins RL, Oliver MB, Kim S, Grantier RL 3rd, Malhotra BK, Parham JJ, Stover KR. A case of Ignatzschineria indica bacteremia following maggot colonization. Case Rep Infect Dis 2017;2017:3698124. https://doi.org/10.1155/2017/3698124
- 24. Rodriguez-Zuniga D, Gonzalez-Galiano N, Leal-Negrado A, Hidalgo-Perez E. First case of sepsis by Ignatzschineria in Spain associated with myiasis. Description of a case and review of the literature. Enferm Infecc Microbiol Clin 2019;37:64-65. https://doi.org/10.1016/j.eimc.2018.02.009
- 25. Roudiere L, Jean-Pierre H, Comte C, Zorgniotti I, Marchandin H, Jumas-Bilak E. Isolation of Schineria sp. from a man. Emerg Infect Dis 2007;13:659-661. https://doi.org/10.3201/eid1304.061255
- 26. Snyder S, Singh P, Goldman J. Emerging pathogens: a case of Wohlfahrtiimonas chitiniclastica and Ignatzschineria indica bacteremia. IDCases 2020;19:e00723. https://doi.org/10.1016/j.idcr.2020.e00723
- 27. Aubertin N, Gavand PE, Korganow AS, Vogel T, Jehl C, editors. Septicémie à Ignatzschineria larvae à point de départ cutané chez un patient de 76 ans avec ulcère artériel malléolaire colonisé par des larves de mouches. L’année Gérontologique. 2018. 32:p. 115-121 (in French)..
- 28. Release notes MBT RUO library EN DB 6903 [Internet];; Bremen: Bruker Corporation; [cited 2020 May 4]. Available from: ftp://ftp.bdal.de/data/support/tof/MaldiBiotyper/Version6.0.0.0/MBT_Compass_Library_6.0.0.0_6903_EN.pdf
- 29. Sherman RA. Maggot therapy takes us back to the future of wound care: new and improved maggot therapy for the 21st century. J Diabetes Sci Technol 2009;3:336-344. https://doi.org/10.1177/193229680900300215
- 30. Jaklic D, Lapanje A, Zupancic K, Smrke D, Gunde-Cimerman N. Selective antimicrobial activity of maggots against pathogenic bacteria. J Med Microbiol 2008;57:617-625. https://doi.org/10.1099/jmm.0.47515-0
- 31. European Border and Coast Guard Agency. Flash report-Irregular migration into EU at lowest level since 2013 [Internet];; [cited 2020, 18 March]. Available from: https://frontex.europa.eu/media-centre/news-release/flash-report-irregular-migration-into-eu-at-lowest-level-since-2013-n5pHiA
- 32. Republic of Slovenia, Ministry of the Interior. Illegal migration in the Republic of Slovenia in the period from January 1 and December 31, 2019 [Internet]; Ljubljana, Slovenia: Uniformed Police Directorate, Border Police Division, Republic of Slovenia Ministry of the Interior; [cited 2020 March 18]. Available from: https://www.policija.si/eng/areas-of-work/border-matters-and-foreigners/illegal-migration-statistical-data